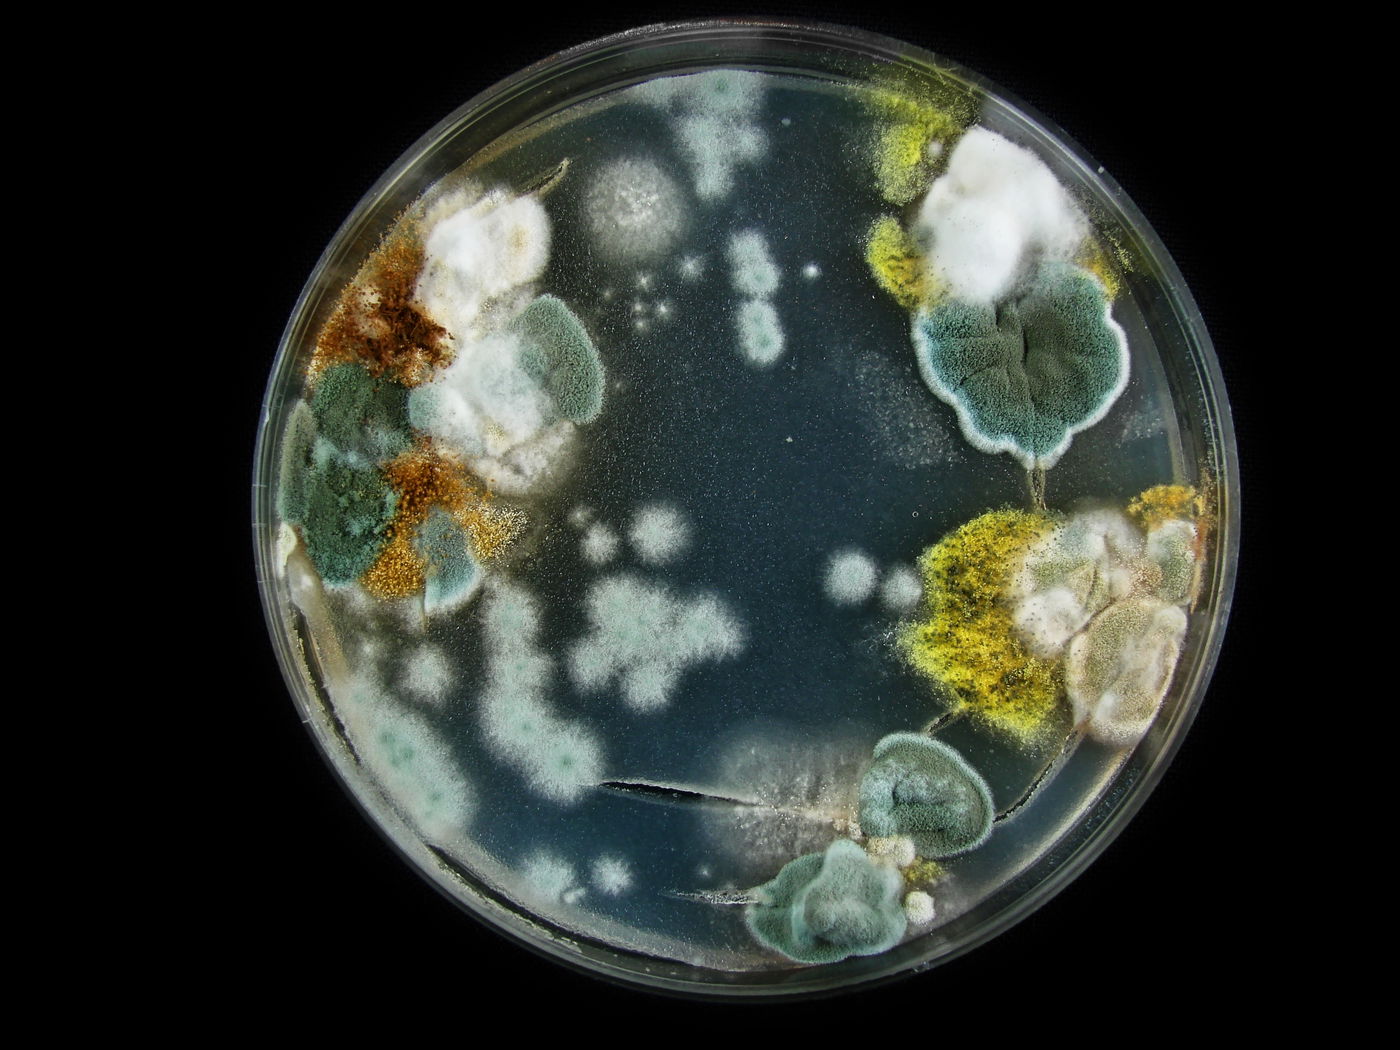
עובש שחור במבט מקרוב

במאי 1997 נכנסה נלי ז’דנובה לאחד המקומות הרדיואקטיביים ביותר על פני כדור הארץ – הריסותיו הנטושות של הכור שהתפוצץ בצ’רנוביל, וגילתה מראה יוצא דופן.
>> למגזין המלא - לחצו כאן
אחת עשרה שנים לפני ביקורה של ז’דנובה, הפך ניסוי בטיחות שגרתי בתחנת הכוח הגרעינית צ’רנוביל שבאוקראינה לאסון הגרעיני הגדול ביותר בהיסטוריה. שגיאות תפעוליות גרמו לפיצוץ עצום ב־26 באפריל 1986, ולשחרור כמות עצומה של חומרים רדיואקטיביים.
כדי לצמצם חשיפה לקרינה, הוקם סביב הכור "אזור סילוק" ברדיוס של שלושים קילומטרים, שמנע מאנשים לשהות בקרבת מוקדי הקרינה החזקה.

אך בעוד בני האדם הורחקו, ז'דנובה גילתה חומר חדש שהחל לכבוש את האזור. על התקרה, הקירות ובתעלות המתכת המגנות על כבלי החשמל התפשט עובש שחור, שתפס לעצמו מקום במרחב שנחשב בעבר קטלני מדי לכל צורת חיים.
מחקריה של ז’דנובה הראו כי הקורים של העובש השחור התנהגו כמו צמחים הנמשכים לאור, אך במקרה זה הם נמשכו דווקא לאזורי הקרינה. העובש, המורכב ממספר סוגי פטריות, לא רק התפשט משום שהעובדים נטשו את המתקן, אלא ממש נדד לעבר חלקיקי הקרינה שפוזרו במקום. ז’דנובה מצאה שהפטריות חדרו עד למקורות הקרינה עצמם – החדרים הפנימיים של הכור שהתפוצץ.
באזורים שונים בצ’רנוביל נראו גם בעלי חיים כמו צפרדעים בעלות עור כהה מהרגיל, כנראה בשל הגנה טבעית בפני הקרינה. ז’דנובה הבחינה שהפטריות השחורות אוגרות מלנין, הפיגמנט המעניק צבע כהה, והוא זה שהפך אותן לשחורות.
המלנין, שמגן על עורנו מפני קרינת UV המגיעה מהשמש, כנראה מסייע גם להגן על תאי הפטריות מפני קרינה הרבה יותר חזקה. המלנין אינו מחזיר את הקרינה אלא בולע אותה וממס את האנרגיה שלה במבנהו הלא־סדור. הוא פועל גם כנוגד חמצון, מנטרל יונים (אטומים טעונים חשמלית) פעילים שנוצרים בעקבות הקרינה.
הממצאים של ז'דנובה טלטלו לחלוטין את ההבנה המדעית לגבי השפעות הקרינה על החיים. תגליותיה יצרו תקווה ליכולת לנקות אזורים מזוהמים רדיואקטיבית, ואף לפתח דרכים להגן על אסטרונאוטים מקרינה מסוכנת במסעות בחלל.

ב־2007 חיזקה החוקרת יקטרינה דאדצ’ובה את ממצאיה של ז’דנובה כאשר גילתה שפטריות יחד עם המלנין לא רק גדלות לכיוון הקרינה, אלא ממש גדלות מהר יותר בנוכחותה. פטריות שנחשפו לצזיום רדיואקטיבי צמחו כעשרה אחוזים יותר מאשר בתרביות ללא קרינה. המלנין, כך סברה דאדצ’ובה, אינו רק מגן – אלא גם מתווך אנרגיה שהופך את הקרינה למקור אנרגטי עבור הפטרייה.
ב־2018 נשלחו פטריות מן הכור בצ’רנוביל לתחנת החלל הבינלאומית, ושם נמצא כי הן גדלו מהר יותר בתנאי חלל לעומת פטריות זהות על פני כדור הארץ. החוקרים ניסו להפריד בין השפעת הקרינה לבין השפעת חוסר הכבידה, אך גם כך נמצא שהפטריות מספקות אפקט מיגון: שכבה דקה של פטרייה הפחיתה את הקרינה שנמדדה מתחתיה.

כל זאת הוביל לרעיון עתידני: שימוש בפטריות כבסיס להגנה מקרינה עבור מושבות ירח או מאדים עתידיות. מים, פלסטיק ומתכת הם חומרים כבדים ומסורבלים להובלה לחלל, ואילו פטריות ניתן לגדל במקום.
חוקרי נאס"א כבר הדגימו קונספט של מבנים ביולוגיים הבנויים מפטריות, שיוכלו לשמש מחסה. המבנים עשויים לשמש כהגנה מפני קרינה קוסמית ואף להתחדש באופן טבעי.
>> למגזין המלא - לחצו כאן
כך התגשם צעד משמעותי נוסף בדרך של האדם להתיישבות אפשרית בכוכבים חדשים.








0 תגובות